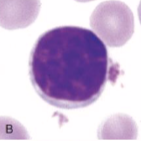
knowt flashcard image

1/74
Looks like no tags are added yet.
Name | Mastery | Learn | Test | Matching | Spaced | Call with Kai |
|---|
No analytics yet
Send a link to your students to track their progress
What are the major leucocytes in circulations
Neutrophils
Monocytes
Lymphocytes
Eosinophils
Basophils
What is WBC count provided by
An automated haematology analyser
What is differential WBC count
Percentages of different leucocyte types
What is the gold standard for differential WBC count
Manual
What is the automated haematology analyser actually counting
Total nucleated cells count rather than total WBC count
How do you do a manual differential WBC count
Count 100 WBC at 40x or 100x moving with battlement pattern
Classify
Calculate absolute numbers by multiplying percentage with total WBC count
What do neutrophils look like

What do lymphocytes look like
What do monocytes look like

What do dog and cat eosinophils look like

What do horse eosinophils look like

What do cow eosinophils look like

What do dog and cat basophils look like

What do horse basophils look like

What do cow basophils look like

How do WBC size compare
Lymphocytes < granulocytes < monocytes
Which WBC have lobed nucleus
Neutrophils
Eosinophils
Basophils
Which WBC have cytoplasmic granules
Eosinophils
Basophils
Where are leucocytes produced
In the bone marrow
In lymphoid tissues
What are the two leucocyte pools in blood
Circulating - freely flowing cells
Marginated - transiently attached to the endothelium
What is the left shift
The hallmark of acute and active inflammation
What are the stages of the left shift
Great demand
Storage neutrophil pool diminishes
Release of immature neutrophils from maturing neutrophil pool
What are band neutrophils
U or S shaped non segmented nucleus
Immature
One stage before segmented neutrophil
What are toxic changes to neutrophils
Foamy cytoplasm
Diffuse cytoplasmic basophilia
Dohle bodies
Asynchronous nuclear maturation
Giant neutrophils
Toxic granules
Maturation defects occurring during accelerated neutropoiesis
How is neutrophilia caused by inflammation
Infection, immune-mediated disease, neoplasia, necrosis
Toxic changes may be seen
Left shift
How is neutrophilia caused by excess of glucocorticoids
Endogenous or exogenous glucocorticoids
Neutrophils up to 2-4x the normal amount
Less pronounced in cats
Lyphopenia, monocytosis, eosinopenia
How is neutrophilia caused by excess of catecholamines
Fear, excitement, exercise
Transient
Up to x2 for dogs or x4 for cats
Lymphocytosis, monocytosis
What are other causes of neutrophilia
Chronic myeloid leukaemia
Paraneoplastic syndrome
How is neutropenia caused by increased use
Overwhelming acute inflammation
Migration of neutrophils to tissue exceeds the release from bone marrow
Left shift is typically present
Toxic changes may be present
How is neutropenia caused by ineffective production
Bone marrow disorder
Infections
Toxic insult
Myelofibrosis, myelophthisis
What are other causes of neutropenia
Endotoxaemia
Immune mediated neutropenia
Haemophagocytic syndrome
Cyclic haematopoiesis of grey collies and FeLV infected cats
How is lymphocytosis caused by chronic inflammation and antigenic stimulation
Mild to occasionally moderate
Reactive lymphocytes, neutrophilia, monocytosis, eosinophilia
How is lymphocytosis caused by excess catecholamines
Fear, excitement, exercise
Transient
Up to x2 in dogs or x4 in cats
Lymphocytosis, monocytosis
How is lymphocytosis caused by lymphoproliferative disease
Leukaemia and leukaemic phase of lymphoma
Mild to extreme lymphocytosis
How is lymphocytosis caused by hypoadrenocorticism
Reverse stress leukogram
How is lymphopenia caused by excess of glucocorticoids
Endogenous or exogenous glucocorticoids
Most frequent cause
How is lymphopenia caused by acute inflammation
Stress
Viral infections
How is lymphopenia caused by depletion
Loss of lymphocyte rich fluid
Enteric disease
Repeated drainage of chylothorax
How is lymphopenia caused by hypoplasia, destruction and disruption of lymphoid tissue
Multicentric lymphoma
Immunosuppressive drugs
What are causes of monocytosis
Inflammation - acute or chronic
Excess of glucocorticoids
Other - secondary to neutropenia, chronic myeloid leukaemia
How is eosinophilia caused by hypersensitivity reactions
Flea bite dermatitis
Feline asthma
Food allergy
How is eosinophilia caused by parasitism
Ectoparasites
Endoparasites
How is eosinophilia caused by inflammation
Idiopathic conditions
Eosinophilic enteritis
Eosinophilic bronchopneumonia
Eosinophilic panosteitis
What are other causes of eosinophilia
Hypoadrenocorticism
CHronic eosinophilic leukaemia or paraneoplastic
Hypereosinophilic syndrome
What are causes of basohilia
Hypersentitivity reactions
Parasitism
Neoplasia
What causes monocytopenia
Healthy animals can have only rare monocytes
Not a diagnostic problem
What causes eosinopenia
Stress leukogram
Healthy animals can have only rare eosinophils
What is haematopoietic neoplasia
Clonal proliferation of lymphocytes or other leucocytes and their precursors
What is haematopoietic neoplasia typically associated with
Marked leucocytosis but reduced numbers of other leucocytes
What characterises acute leukaemia or the leukaemia phase of lymphoma
Poorly differentiated, overtly abnormal cells
What characterises chronic leukaemia or the leukaemia phase of lymphoma
Well differentiated cells
What are platelets
Anucleate cytoplasmic fragments
What is the cytoplasmic appearance of platelets
Pale blue/pink cytoplasm containing clusters of purple granules
What is the origin of platelets
Megakaryocyte in bone marrow
What are thrombocytes in non-mammalian species
True cells
What is platelet count obtained by
The haematology analyser
What is the estimation of platelets in a blood smear
1 PLT/OIF = 15 × 109 /L
10 platelets in 100x oil objective in dogs cats and bovine
5 platelets in 100x oil objective in horses
What causes platelet clumping
In vitro aggregation
Slow or poor venepuncture technique
Delayed or inadequate mixing of blood with anticoagulant
What is thrombocytopenia
Decreased platelet count
When does spontaneous bleeding typically occur in thrombocytopenia
When PLT count <20-30 × 109 /L
What is pseudothrombocytopenia
Falsely low platelet count due to platelet clumping
What should always be done if platelet count is low
Check a blood smear for platelet clumping
Which breeds have breed-specific normal platelet variations
Sighthounds
Cavalier King Charles Spaniel
Norfolk terriers
Cairn terriers
How is thrombocytopenia caused by sequestration and redistribution
Splenomegaly, sever hypothermia, endotoxaemia
Mild to occasionally moderate in severity
How is thrombocytopenia caused by increased consumption
DIC, thrombosis, vascular neoplasm, vasculitis, massive acute blood loss
Large platelets may be seen
How is thrombocytopenia caused by increased destruction
Autoimmune, infectious agents, drugs, neoplasia
Large platelets may be seen
How is thrombocytopenia caused by inadequate production
Decreased or ineffective production
Idiopathic, infectious agents, drugs, toxins, myelophthisis, myelodysplasia
What are the clinical signs of thrombocytopenia
Petechiae - haemorrhages in skin
Ecchymosis - mucosal haemorrhage
Epistaxis - nose bleeds
Melaena - digested blood if faeces
Maematochezia - blood in faeces
Haematuria - blood in urine
What is thrombocytosis
Increased platelet count
Usually no clinical significance unless extreme
What are the causes of thrombocytosis
Splenic contraction
Inflammation
Neoplasia
Iron deficiency anaemia
Post splenectomy
Hypercortisolaemia
Drugs
What are large/giant platelets
Platelets seen on a blood smear or identified by increased MPV
When is a platelet considered giant
If it is bigger than a RBC
In which species are large platelets common in healthy individuals
Cats
What do large/giant platelets suggest
Accelerated and active thrombopoiesis
What is inherited macrothrombocytopenia
A breed specific normal variation
Not associated with bleeding diathesis
Common in cavelier king charles spanial, norfolk terrier and cairn terriers